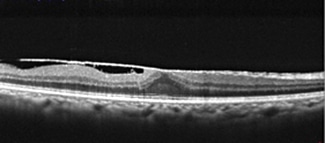

黄斑上膜(網膜前膜)とは
手術が必要な目の病気で、最も有名なものは白内障です。
では黄斑上膜(網膜前膜)という病気はご存知でしょうか??
黄斑上膜は眼球内部の一番奥の部分、眼底といわれる部分の病気です。
光が角膜と水晶体を通り抜けた後、目の奥にある「網膜」に像を結び、その情報が脳に伝えられてモノが見える仕組みになっています。
この網膜の中でも特に中心部分にあたるところを「黄斑」と呼びます。
黄斑の上(表現によっては前)に膜が貼ってきて、網膜にしわが寄ったり盛り上がって形態以上をきたした状態が黄斑上膜(網膜前膜)です。
症状は、以下のものです。
・モノが歪んで見える
・ぼやけてで見える
原因は、
・加齢にともなうもの
・網膜剥離の術後
・ぶどう膜炎などの既往
です。
治療は通称、「硝子体手術」といわれるものを行います。
当院は白内障手術を多く手掛けていますが、実は網膜硝子体疾患の治療を得意としており、福岡でも有数の硝子体手術のできるクリニックです。
入院の必要はなく、手術時間も30分程度です。
1日だけ眼帯をしていただくことになりますが、翌日には眼帯もとれ、運転も可能になります。
しかし、視力や症状の改善にはある程度の日数を要するため運転等は慎重に行う必要があります。
個人差や、手術前の状態によりますが、術後2日目ですでに視力が1.0に回復している人もいます。
硝子体手術は白内障手術よりも技量や経験が必要になるため、多くの場合、疾患が見つかったら大学病院に紹介になることも多いかと思います。
当院ではほぼ毎週のように硝子体手術を行なっており、そのすべてが日帰り手術になります。
現代の眼科手術で入院が必要なものは数える程しかありません。
日帰り手術であればそれまでの生活スタイルを大きく変えることなく治療を行うことができるため安心です。
手術適応は眼科によって異なることがあります。
まだ病状が軽いうちから手術を勧める病院、とっくに悪くなっているのにまだ手術は必要ないという病院。。。
判断に迷った際にはセカンドオピニオンも承っております。
網膜硝子体(もうまくしょうしたい)手術|福岡の川原眼科 (kawahara-ec.jp)
福岡で黄斑上膜の治療なら
粕屋町の川原眼科へ























